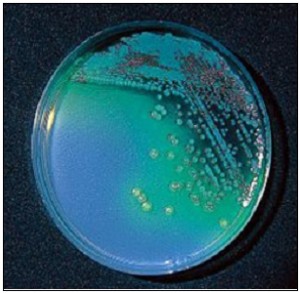
C

Cetrimide Agar (Base) – Medio Selectivo para Pseudomonas aeruginosa (Farmacopea USP / ISO 22717)
El Cetrimide Agar (Base) es un medio sólido selectivo diseñado para el aislamiento y diferenciación de Pseudomonas aeruginosa en medicamentos, cosméticos y otros productos según las normas de la Farmacopea USP y la ISO 22717.
Desarrollado conforme a los más altos estándares de calidad microbiológica, este medio favorece la producción de fluoresceína y piocianina, pigmentos característicos que facilitan una identificación rápida y fiable de la especie.
⚗️ Composición (por litro)
- Peptona pancreática de gelatina: 20,0 g
- Cetrimida: 0,3 g
- Cloruro magnésico: 1,4 g
- Sulfato dipotásico: 10,0 g
- Agar-agar: 13,6 g
- pH final: 7,2 ± 0,2
Preparación del Medio
- Disolver 44,5 g de medio en 1 litro de agua destilada.
- Añadir 10 ml de glicerol.
- Calentar hasta ebullición, agitando suavemente para su completa disolución.
- Autoclavar a 121 ºC durante 15 minutos.
- Conservar el bote bien cerrado, en un lugar fresco, seco y protegido de la luz.
- Agitar antes de usar.
Uso exclusivo en laboratorio.
Código de producto: DMT034
Presentación: Medio deshidratado (base + suplemento de glicerol)
Control de Calidad
El control de calidad se realiza en nuestro laboratorio, siguiendo la ISO/TS 11133.
Se recomienda repetirlo en el laboratorio del usuario si han transcurrido más de 3 meses sin uso, tras una desinfección general, exposición a altas temperaturas o si el medio presenta alteraciones visuales.
Aspecto del producto:
- Deshidratado: Polvo grueso, blanco.
- Preparado: Estéril, color blanco.
Control de crecimiento (48 h a 37 °C o 21–28 °C):
| Microorganismo | Resultado | Observaciones |
|---|---|---|
| Pseudomonas aeruginosa MKTA 27853 | Bueno, pigmenta | Colonias verde-amarillentas fluorescentes; recuento 92–99% respecto a TSA |
| Burkholderia cepacia MKTA 25416 | Correcto | Colonias blancas-crema; recuento 72% respecto a TSA |
| Staphylococcus aureus MKTA 6538P | Inhibido | — |
| Escherichia coli MKTA 25922 | Inhibido | — |
Cumple con una recuperación superior al 92–125% respecto a cepas cuantitativas trazables a la cepa tipo.
Presentación Disponible
- Tubos: 20 ml
- Frascos: 100 ml
- Placas 90 mm y plaquis® 55 mm
- Medio deshidratado base + suplemento (glicerol)
Características y Aplicaciones
- Medio selectivo para Pseudomonas aeruginosa según USP XXI.
- El cetil trimetil amonio bromuro (cetrimida), base de amonio cuaternario, inhibe la flora acompañante.
- Estimula la producción de pigmentos fluorescentes (fluoresceína y piocianina), indicadores diferenciales de P. aeruginosa.
- Recomendado para control microbiológico de calidad en medicamentos y cosméticos, de acuerdo con ISO 22717.
Procedimiento de Siembra
- Fundir el contenido del tubo o frasco y verter 20 ml en una placa de Petri estéril.
- Dejar enfriar hasta solidificar.
- Sembrar en estría, en superficie, una muestra del cultivo.
- En el caso de placas de contacto, aplicar sobre la superficie unos segundos sin mover.
- Incubar a 37 ºC durante 18–42 horas.
Interpretación de Resultados
- Pseudomonas aeruginosa: Colonias verde-amarillentas fluorescentes (más visibles bajo luz UV de 366 nm, linterna MICROKIT). También pueden observarse tonos marrones.
- Confirmar la identidad mediante:
- Tira de citocromo oxidasa (Ref. KOT050).
- Galerías de identificación MICROKIT® (Ref. 245000).
- Tubos de caldo Acetamida (Ref.TPL113) con reactivo Nessler (Ref.SDA002)
⚠️ Precauciones de Uso
- Producto para uso exclusivo en laboratorio.
- No ingerir ni inhalar.
- Evitar exposición prolongada a la luz o la humedad.
- Contiene compuestos de amonio cuaternario (cetrimida), potencialmente irritantes.
- Usar exclusivamente asas de platino (Ref. VCS147), o desechables de plástico (Ref.302750D), nunca de nicrom.
- Desechar el material biológico conforme a la legislación medioambiental vigente.
Si desea más información y precios actualizados sobre nuestros MEDIO CETRIMIDE AGAR (BASE) póngase en contacto con nosotros a través de nuestro correo electrónico microkit@microkit.es o por teléfono en el nº 91-897 46 16.
https://www.microkit.es/fichas/CETRIMIDE-AGAR.pdf
https://www.microkit.es/monograficos/13-Pseudomonas-aeruginosa-monograf–a.pdf

deseo obtener un poco mas de informacion.
Buenos días:
Respondemos su consulta desde nuestro correo general.
Muchas gracias por visitar nuestro blog y contactar con nosotros.
Un saludo
mas informacion.